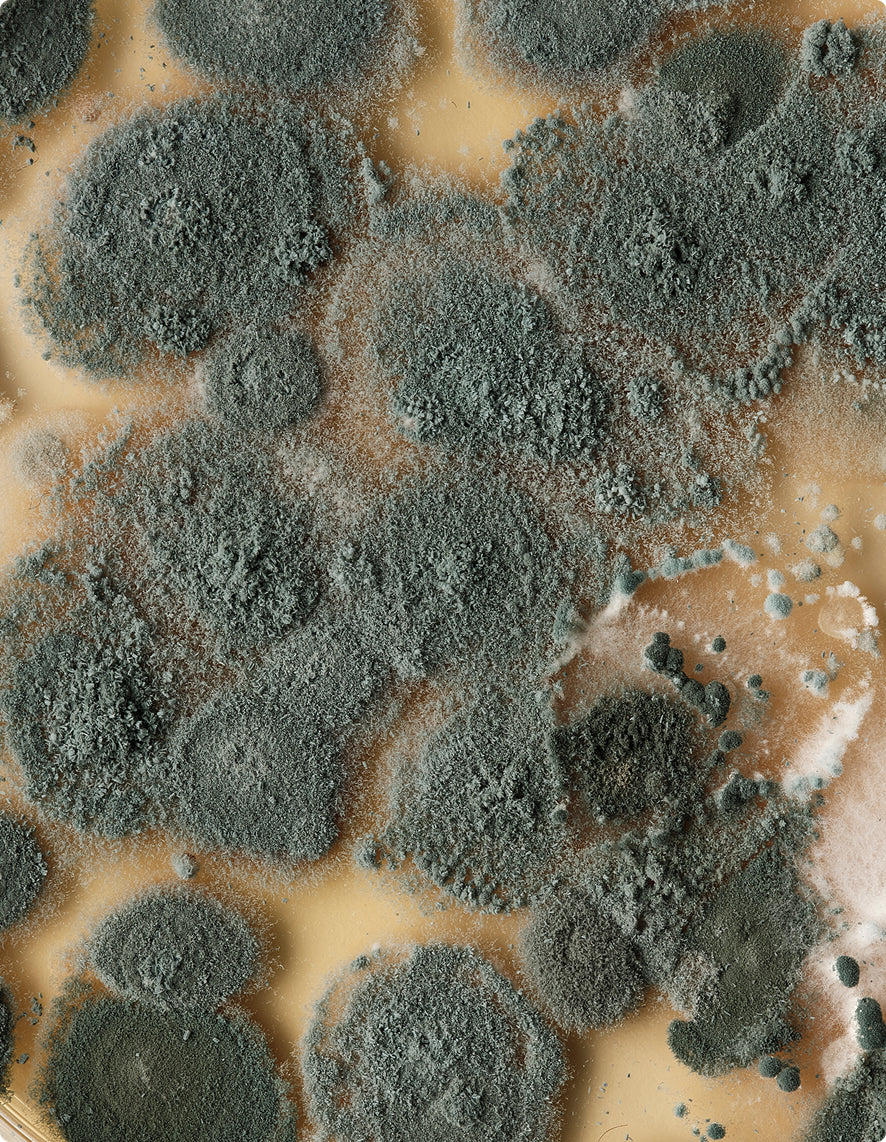

The Fade 101
Timeless, versatile, made for everyday life.
Your new favorite sneaker: classic in look, uncompromising in design. Built with craft and compost-capable materials, the Fade 101 is designed on purpose, built to last, and Made to Fade back into nature.
Features & Benefits
Timeless design
Everyday wear, effortless style. Fade 101 is simple, versatile, and built to look good with everything, the kind of sneaker that never feels out of place.
Compost-capable materials
Leather, laces, foam, even the lace tips. Every part is chosen to safely return to nature. Nothing toxic, nothing extra, just materials that can safely return to nature.
Comfort you feel
A buttery-soft natural rubber outsole cushions each step, while a breathable plant-fiber lining keeps things fresh. Comfort you notice the moment you put them on, and feels even better over time.
Durable by nature
Compost-capable doesn’t mean fragile. Fade 101 is built to handle rain, daily miles, and the knocks of real life, while holding its shape until its journey is done.
Made to Fade
When your SOLKs have done their miles, send them back. We’ll compost them the right way, closing the loop so they return safely to the earth.
Materials
See All MaterialsFull-Leather Upper
Made from chrome-free, heavy metal-free leather, responsibly tanned in Germany for strength and softness. Durable, beautiful, and safe to compost.
Biobased Knitted Lining
A zero-waste knitted lining keeps the shoe breathable and comfortable. Crafted to shape from biobased fibers, leaving no scrap behind.
Natural Rubber Sole
Hand-tapped from trees and naturally resilient, providing comfort, grip and durability underfoot. From nature to nature.
Fade Foam
”70% nothing” makes this unique material super spongy for all day wear, yet durable, and fully compost-capable at end-of-life.
Compostable Aglets
Even the lace tips are considered. Specially developed to be easy to compost.
Biobased Glue
Chosen to hold firm through wear, and fade cleanly at the end.